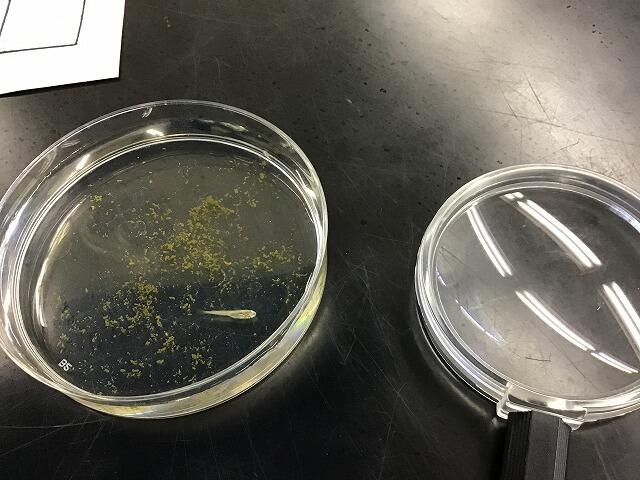

文字
背景
行間
令和5年度まで
ひまわり学級より
畑のナスやトマトが ぐんぐん大きくなり,まっかでおいしそうな トマトがなりました。かぼちゃも花がさき,みんなでかん察や 収かくをしています。
見つけたザリガニの かん察をしました。ものさしの使い方を 学んだばかりの2年生は,さっそく体やはさみの 大きさをはかりました。
めだかの赤ちゃんも 仲間入りしたので,4年生から6年生が,かん察しました。

先生紹介や,英語のダンスを 教える活動をしています。みんなの前でダンスをしたり 先生達の好きなものを発表したりしています。休み時間には、クイズやけい示物を全校のみんなが みに来てくれています。

療養報告書及び感染症一覧
名札の購入
名札の購入については,以下のファイルをご確認ください。
リンク
カウンタ
2
2
9
4
8
2
1